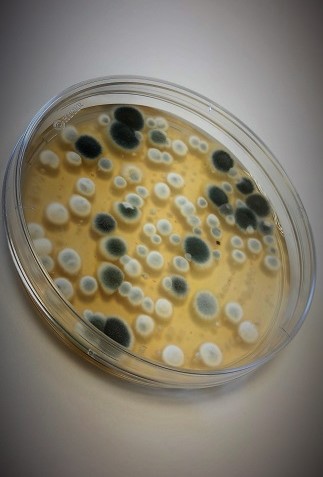

Matråd AS tilbyr luftprøvetaking og analyse av mugg- og gjærsopp i næringsmiddelbygg. Mugg- og gjærsopp kan ha negativ innvirkning på inneklimaet og dersom du driver næringsmiddelvirksomhet redusere kvaliteten på produktet. Målingen foretas ved bruk av luftsampler og mugg/gjær dyrkningsmedium (DG18). Svaret oppgis som kolonier per m3.
![]() Les mer: Luftprøver - mugg i innelufteluft
Les mer: Luftprøver - mugg i innelufteluft